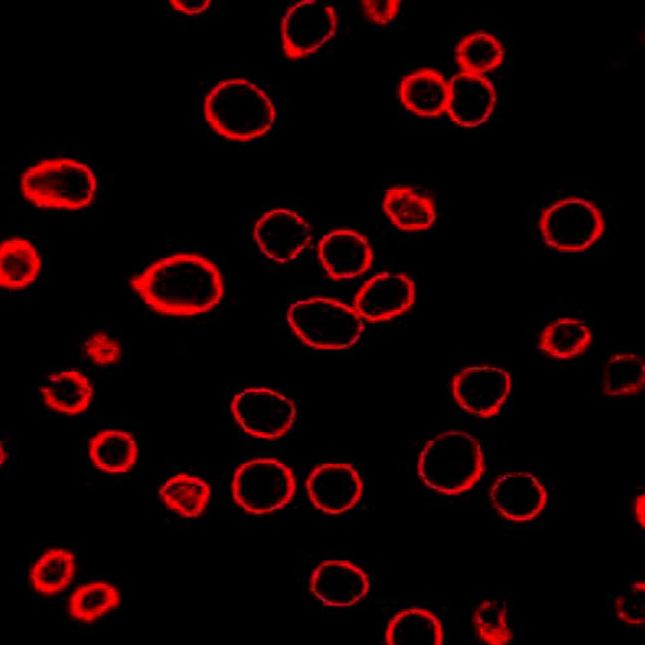
DiD（细胞膜红色荧光探针）

相关产品推荐更多 >
万千商家帮你免费找货
0 人在求购买到急需产品
- 详细信息
- 技术资料
- 供应商:
武汉恩玑生命科技有限公司
- 规格:
10mg
基本信息
|
中文名称 |
DiD(细胞膜红色荧光探针) |
|
英文名称 |
DiD |
|
产品规格 |
10mg |
|
存储条件 |
-20℃,避光保存 |
|
运输条件 |
低温 |
|
有效期 |
12个月 |
DiD激发/发射波长:644/663nm
产品介绍
DiD染料是亲脂性荧光染料家族成员之一,它可以用来染细胞膜和其它脂溶性生物结构。当DiD与细胞膜结合后其荧光强度大大增强,这类染料有着很高的淬灭常数和激发态寿命。一旦对细胞染色,这类染料在整个细胞膜上扩散,最佳浓度时可以使整个细胞膜染色。DiD(远红色荧光)可以用来对活细胞进行成像和流式分析。DiD可以用633 nm He–Ne激光器激发,有着比DiI(一种常见的细胞荧光染料)更长的激发波长和发射波长,在细胞和组织染色中更有价值。
试剂制备
(1)配制储液:储液用无水 DMSO 或 EtOH 配制,浓度 1~5 mM。
注:未使用的储存液分装储存在-20℃,避免反复冻融;
(2)工作液制备:用合适的缓冲液(如:无血清培养基,HBSS 或 PBS)稀释储液,配制浓度为 1~5 μM 的工作液。
注:工作液最终浓度建议根据不同细胞系和实验体系来优化。建议从推荐浓度的 10 倍范围内开始zui优浓度的摸索。
备注:该试剂仅供科研使用!
风险提示:丁香通仅作为第三方平台,为商家信息发布提供平台空间。用户咨询产品时请注意保护个人信息及财产安全,合理判断,谨慎选购商品,商家和用户对交易行为负责。对于医疗器械类产品,请先查证核实企业经营资质和医疗器械产品注册证情况。
技术资料暂无技术资料 索取技术资料
DiD(细胞膜红色荧光探针)
¥540